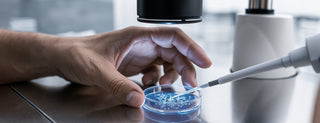

DERM RECOMMENDED
INGREDIENTS
35 patents & more to come
Backed by 35+ patents, RoC elevates dermatologist recommended ingredients like Retinol, Vitamin C, Hyaluronic Acid, and Peptides to a new standard of clinically proven efficacy.
RoC clinical RETINOL
America’s #1 Retinol
RoC Skincare—the first brand to stabilize Retinol—continues to lead in Retinol innovation with 26 patents, backed by decades of research and trusted by dermatologists worldwide.
Building on this legacy, RoC introduces its new Patented Clinical Retinol, clinically proven to deliver 7x more wrinkle reduction than standard Retinol—yet gentle enough for sensitive skin, safe for year-round use, and effective on all skin types.
RoC Skincare—the first brand to stabilize Retinol—continues to lead in Retinol innovation with 26 patents, backed by decades of research and trusted by dermatologists worldwide.
Building on this legacy, RoC introduces its new Patented Clinical Retinol, clinically proven to deliver 7x more wrinkle reduction than standard Retinol—yet gentle enough for sensitive skin, safe for year-round use, and effective on all skin types.
ROC VITAMIN C
BEYOND BRIGHTENING
Not all Vitamin C is created equal. The most studied, stable & effective- RoC’s Vitamin C is a patent-pending blend that delivers unmatched brightening power, safe enough for daily use. Supercharged with a Nonapeptide and radiance-boosting Antioxidants that offer protection against environmental and photo-damage, this powerhouse formula protects and delivers radiant, healthy-looking skin—now and in the future.
Not all Vitamin C is created equal. The most studied, stable & effective- RoC’s Vitamin C is a patent-pending blend that delivers unmatched brightening power, safe enough for daily use. Supercharged with a Nonapeptide and radiance-boosting Antioxidants that offer protection against environmental and photo-damage, this powerhouse formula protects and delivers radiant, healthy-looking skin—now and in the future.
ROC HYALURONIC ACID
10 LAYER ACTION
Not all hyaluronic acids are created equal. Backed by over 30 years of clinical expertise, we’ve chosen 7 unique forms of hyaluronic acid that penetrate 10 layers deep to deliver up to 100 hours of intense moisturization within skins surface. With continued use, these advanced molecules are designed to provide visible results instantly and over time: dramatic volume, improved skin texture and elasticity. Even RoC products that include a standard form of RoC Hyaluronic Acid behaves like a sponge, locking in moisture for a visibly plump, smooth and healthy appearance.
Not all hyaluronic acids are created equal. Backed by over 30 years of clinical expertise, we’ve chosen 7 unique forms of hyaluronic acid that penetrate 10 layers deep to deliver up to 100 hours of intense moisturization within skins surface. With continued use, these advanced molecules are designed to provide visible results instantly and over time: dramatic volume, improved skin texture and elasticity. Even RoC products that include a standard form of RoC Hyaluronic Acid behaves like a sponge, locking in moisture for a visibly plump, smooth and healthy appearance.
ROC HEXYL-R COMPLEX
BEYOND DARK SPOT TREATMENT
After 7 years of research, this multi-action technology was developed to target the visible signs of aging with a different approach than other anti-aging ingredients, impacting the signs of aging even before they become evident. Hexyl-R Complex™ Technology improves a wide range of visible signs of aging—from uneven skin tone to diminished radiance caused by environmental stress. It works differently than many other skincare ingredients and is clinically proven to be four times more effective than a leading ingredient at visibly improving skin tone, including the appearance of age spots. Hexyl-R Complex also delivers antioxidant protection against environmental damage and mild astringent benefits for refined, healthier-looking skin.
After 7 years of research, this multi-action technology was developed to target the visible signs of aging with a different approach than other anti-aging ingredients, impacting the signs of aging even before they become evident. Hexyl-R Complex™ Technology improves a wide range of visible signs of aging—from uneven skin tone to diminished radiance caused by environmental stress. It works differently than many other skincare ingredients and is clinically proven to be four times more effective than a leading ingredient at visibly improving skin tone, including the appearance of age spots. Hexyl-R Complex also delivers antioxidant protection against environmental damage and mild astringent benefits for refined, healthier-looking skin.


$29.99
- Unit price
- /per


$34.99
- Unit price
- /per


$28.49
- Unit price
- /per


Regular price
$43.98
$37.99
- Unit price
- /per


$24.99
- Unit price
- /per









